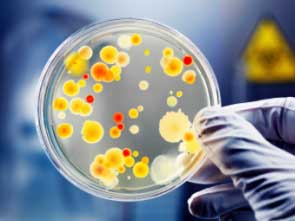

Что это такое
Параметр PDW обозначает относительную ширину распределения тромбоцитов в определенном объеме. Он возник из-за разнообразия формы и структуры клеток крови. Молодые тромбоциты, как правило, имеют больший объем по сравнению со старыми. В дополнение к PDW, анализируются и другие показатели тромбоцитов, что позволяет получить более полное представление о состоянии крови.
К тромбоцитарному индексу относятся:
- Общее количество тромбоцитов.
- Их средний объем.
- Распределение тромбоцитов по объему и ширине.
На основании этих данных врач может оценить свертываемость крови и риск развития различных заболеваний. Если PDW находится в пределах небольших отклонений, а остальные показатели соответствуют норме, то на него не обращают особого внимания.
PDW, или индекс распределения тромбоцитов, является важным показателем в анализе крови, который отражает вариабельность размера тромбоцитов. Врачи отмечают, что изменения в PDW могут указывать на различные заболевания, включая воспалительные процессы и нарушения гемостаза. Высокий уровень PDW может свидетельствовать о наличии воспаления или других патологий, тогда как низкий уровень может быть связан с тромбоцитопенией.
Чтобы скорректировать уровень PDW, специалисты рекомендуют обратить внимание на образ жизни и питание. Увеличение потребления продуктов, богатых витаминами и минералами, таких как фрукты, овощи и орехи, может помочь улучшить состояние крови. Также важно следить за уровнем физической активности и избегать стрессов. В случае значительных отклонений от нормы врачи могут назначить дополнительные исследования и, при необходимости, медикаментозное лечение. Регулярные анализы крови помогут контролировать уровень PDW и своевременно выявлять возможные проблемы со здоровьем.

Как подготовиться к анализу
Для получения точных результатов анализа крови необходима предварительная подготовка. Врачи выделяют несколько факторов, которые могут существенно повлиять на важные показатели:
- Интенсивные физические нагрузки. Они могут увеличить частоту сердечных сокращений и изменить состав крови.
- Прием медикаментов. Рекомендуется перенести употребление лекарств на другое время. Однако такие изменения следует согласовать с лечащим врачом, а не делать самостоятельно.
- Менструальный цикл. В период критических дней уровень тромбоцитов снижается, что может исказить результаты анализа.
- Беременность. Этот период значительно увеличивает свертываемость крови и количество тромбоцитов.
- Употребление пищи перед анализом. Рекомендуется, чтобы после еды прошло не менее 8 часов.
- Физиотерапевтические процедуры, проведенные незадолго до сдачи анализа.
- Воздействие рентгеновских лучей.
Подготовка к анализу должна включать не только физические аспекты, но и психологические. Страх перед процедурой или стрессовая ситуация в коридоре могут повлиять на состав крови. Поэтому перед забором материала рекомендуется провести несколько минут в спокойствии и расслаблении. Только после этого стоит направляться в кабинет для анализа.
| Показатель PDW | Возможные причины повышения PDW | Рекомендации по коррекции |
|---|---|---|
| Повышенный PDW (широкое распределение тромбоцитов по объему) | Дефицит витаминов группы В (В12, фолиевая кислота), алкоголизм, инфекционные заболевания, аутоиммунные заболевания (например, системная красная волчанка), злокачественные новообразования, сепсис, лекарственные препараты (например, гепарин), спленомегалия, тромбоцитопения | Устранение основной причины (лечение инфекции, коррекция дефицита витаминов, отмена лекарственных препаратов), гемостатическая терапия при необходимости, консультация гематолога |
| Нормальный PDW | Здоровый костный мозг, адекватное производство тромбоцитов | Поддержание здорового образа жизни, сбалансированное питание |
| Низкий PDW (узкое распределение тромбоцитов по объему) | Апластическая анемия, миелодиспластический синдром, после химиотерапии | Лечение основного заболевания, поддерживающая терапия (например, переливание тромбоцитов) |
Проведение анализа
Обследование можно пройти в любое время, которое удобно для пациента, особенно в частных медицинских учреждениях. Тем не менее, специалисты советуют сдавать анализы крови утром натощак, чтобы минимизировать влияние различных факторов на результаты.
Для диагностики можно использовать как капиллярную, так и венозную кровь. Венозная кровь позволяет получить большее количество материала и информации, что способствует повышению качества исследований и точности результатов.
У детей проще взять кровь через небольшой прокол в пальце, чем проводить длительный забор из вены.
PDW, или индекс распределения тромбоцитов, является важным показателем в анализе крови, который отражает вариативность размера тромбоцитов. Многие люди не знают, что этот параметр может указывать на различные заболевания, включая воспалительные процессы и нарушения в системе кроветворения. Повышенный уровень PDW может свидетельствовать о наличии воспаления или других патологий, тогда как пониженный — о возможных проблемах с костным мозгом.
Корректировать PDW можно через изменение образа жизни и питания. Врачи рекомендуют включить в рацион больше продуктов, богатых витаминами и минералами, особенно витаминами группы B и C, которые способствуют нормализации кроветворения. Также важно следить за уровнем стресса и заниматься физической активностью, что положительно сказывается на общем состоянии организма. В случае значительных отклонений от нормы, необходимо обратиться к врачу для дальнейшего обследования и назначения соответствующего лечения.

Готовность анализа
После сбора необходимого объема материала медсестра незамедлительно отправляет его на анализ. Время получения результатов зависит от ряда факторов:
- Нагрузка на лабораторию.
- Уровень современности используемого оборудования.
- Число сотрудников.
- Тип реактивов.
Обычно общий анализ крови становится доступным в течение 2 дней. В частных клиниках, оснащенных новейшими технологиями, сроки могут быть сокращены до 1 дня.
Расшифровка
Пациент получает результаты анализа на специальном бланке. В этой форме могут быть указаны как сопоставления полученных данных с нормальными значениями, так и величина отклонений от нормы.
Расшифровка анализа может быть выполнена самостоятельно, если известны нормальные показатели PDW в крови. Для каждой возрастной группы и пола существуют свои допустимые пределы значений.

У мужчин
У взрослого человека количество зрелых и молодых тромбоцитов должно быть равным. Разница между ними не должна превышать 10%.
Если это условие не выполняется, существует риск образования тромбов. У мужчин нормальный уровень pdw в крови составляет 15-17%.
У лиц женского пола
Нормальные показатели у женщин зависят от времени проведения анализа. Существует три ключевых периода, в течение которых эти показатели могут изменяться:
- Обычное состояние. В этом случае нормы аналогичны мужским и составляют 15-17%.
- Менструальный цикл. В этот период значение относительной ширины распределения тромбоцитов снижается. Анализ в это время не рекомендуется, так как уровень снижения PDW у каждой женщины индивидуален.
- Беременность. Гормональные изменения в организме могут привести к смещению тромбоцитарных индексов. Нормальными считаются значения в диапазоне от 10 до 20%.
У детей
Ребенком считается человек в возрасте до 18 лет. В здоровом организме уровень нормы у детей колеблется от 10 до 15%. В период гормональных изменений допустимы отклонения на 1 или 2% от установленных значений.
Причины нарушений
Изменение лишь одного показателя PDW не всегда указывает на наличие серьезных заболеваний в организме. Однако, если несколько показателей оказываются вне нормальных значений, это может указывать на наличие определенных заболеваний.
Окончательный диагноз устанавливается после проведения дополнительных исследований, направленных на выявление конкретной патологии.
Причины высокого показателя
Превышение нормы показателя PDW указывает на значительную неоднородность тромбоцитов. Длительное пребывание в таком состоянии может привести к патологическим изменениям в организме.
Это приводит к снижению кровообращения в капиллярах тканей, что может вызвать их постепенную закупорку и недостаток кислорода для клеток. Основные причины повышения PDW включают:
- Кровотечения после хирургических вмешательств.
- Анемию.
- Онкологические заболевания, влияющие на состав крови.
- Воспалительные процессы. Высокие значения PDW и лейкоцитов указывают на наличие воспаления в организме.
Когда пациент получает информацию о том, что его уровень PDW отклонился от нормы, у него могут возникнуть опасения по поводу серьезных заболеваний. Однако изменения в составе крови не всегда свидетельствуют о наличии патологии. Неправильная подготовка к анализу может привести к искажению результатов.
Причины низкого показателя
Когда уровень PDW опускается ниже 10%, это свидетельствует о его снижении. Уменьшение количества плоских тел является не менее серьезной проблемой, чем их увеличение. Это может привести к нарушению целостности кровеносной системы, что, в свою очередь, негативно сказывается на функционировании других органов.
К основным причинам, вызывающим низкий уровень данного показателя, специалисты относят:
- Патологические изменения в органах, отвечающих за кроветворение.
- Недостаток витамина B12 и фолиевой кислоты.
- Применение цитостатиков.
- Нарушения в работе печени.
- Наличие инфекций или вирусов в организме.
- Онкологические заболевания.
- ДВС-синдром.
Чаще всего клинический анализ может быть искажен у женщин в период приближения или во время менструации. Неправильное питание и малоподвижный образ жизни также могут способствовать изменению уровня PDW.
Не следует игнорировать даже небольшие отклонения от нормы. Важно приложить все усилия для восстановления нормальных значений.
Мероприятия по снижению уровня PDW
На состав крови оказывают влияние различные факторы. В связи с этим существует множество способов для восстановления нормальных показателей. Выбор подходящего метода должен осуществляться исключительно под наблюдением врача.
Использование медикаментов
Существует множество медикаментов, которые помогают разжижать кровь. Их эффект может быть как краткосрочным, так и длительным. Наиболее известные из таких средств включают:
- Аспирин.
- Варфарин.
- Тромбо АСС.
- Клопидогрел.
Эти препараты действуют по-разному и имеют свои противопоказания. Не рекомендуется самостоятельно выбирать и приобретать такие лекарства.
Народная медицина
Восстановление здоровья возможно и без применения медикаментов. Основным союзником в этом процессе является народная медицина. Рассмотрим несколько эффективных рецептов:
-
Измельчите корень имбиря до состояния кашицы и смешайте его с медом в равных пропорциях. Полученную массу поместите в холодильник на 3 дня. Курс лечения составляет 10 дней. Рекомендуется ежедневно, натощак, принимать по 1 столовой ложке этой имбирной смеси. Учитывайте, что оба ингредиента могут вызывать сильные аллергические реакции, поэтому начинать стоит с 0,5 чайной ложки для проверки переносимости.
-
Измельчите 5 зубчиков чеснока с помощью пресса. Полученную массу смешайте с 100 мл водки и оставьте в темном месте на 14 дней. Затем каждое утро принимайте по 1 чайной ложке этого средства перед едой.
Перед использованием народных средств обязательно проконсультируйтесь с вашим лечащим врачом. Если ваше состояние ухудшается, прием препарата следует немедленно прекратить.
Питание
Прежде чем снижать уровень PDW в крови с помощью медикаментов, рекомендуется внести изменения в рацион питания. Пациенту следует перейти на диетическое меню. Корректировка питания осуществляется за счет включения в рацион продуктов, способствующих разжижению крови:
- Свежих овощей и фруктов.
- Имбиря, чеснока и лука.
- Вишни, шиповника и смородины.
- Льняного и оливкового масел.
- Лимонов и клюквы.
- Горького шоколада.
Ключевым условием является отказ от кофе, алкогольных напитков и курения. Рекомендуется заменить все чаи на обычную воду.
Инструментальные меры
Если все имеющиеся методы и средства не принесли заметного эффекта, пациенту может быть рекомендована процедура искусственного очищения крови.
В этом процессе применяется сепараторный аппарат, который задерживает тромбоциты, что приводит к снижению уровня PDW.
Мероприятия по увеличению показателя
Увеличить показатели PDW возможно благодаря различным методам. Решение о применении каждого из них принимает лечащий врач, который имеет полное представление о клинической ситуации пациента.
С помощью медикаментов
В зависимости от причины уменьшения объема тромбоцитов, подбирается соответствующее медикаментозное лечение. К числу таких препаратов относятся:
- Седокор.
- Викасол.
- Деринат.
- Дицинон.
После проведения серьезных процедур, таких как химиотерапия, восстановление нормального уровня тромбоцитов осуществляется с помощью гормональных средств.
Корректировка питания
Питание пациента играет ключевую роль в образовании тромбоцитов. Важно, чтобы рацион содержал достаточное количество белков и зеленых овощей. К основным продуктам, способствующим этому, можно отнести:
- Нежирное красное мясо.
- Яйца.
- Кунж
Прием витаминов
Витамины В12 и С могут способствовать восстановлению уровня PDW в организме. Эти витамины быстро усваиваются и начинают процесс нормализации состава крови.
В сочетании с правильным питанием, полезные добавки могут помочь привести в порядок показатели общего анализа крови.
Профилактика
Чтобы избежать ситуации, когда возникает вопрос о том, что представляет собой отклонение от нормы показателя PWD, важно заранее предпринять профилактические шаги.
Соблюдение режима питья, отказ от вредных привычек и активный образ жизни способствуют поддержанию здоровья на протяжении многих лет.
Вопрос-ответ
Что такое PDW и какую роль он играет в анализе крови?
PDW (Platelet Distribution Width) — это показатель, отражающий вариабельность размеров тромбоцитов в крови. Он используется для оценки состояния гемостаза и может помочь в диагностике различных заболеваний, таких как тромбоцитопения или тромбоцитоз. Высокий уровень PDW может указывать на наличие воспалительных процессов или других патологий.
Как можно скорректировать уровень PDW в анализе крови?
Коррекция уровня PDW зависит от причины его изменения. Если высокий PDW связан с воспалением, то лечение основного заболевания может помочь нормализовать этот показатель. Важно также следить за уровнем витаминов и минералов, таких как витамин B12 и фолиевая кислота, которые влияют на образование тромбоцитов. В некоторых случаях может потребоваться медикаментозное лечение, назначенное врачом.
Какие факторы могут влиять на уровень PDW в анализе крови?
На уровень PDW могут влиять различные факторы, включая возраст, пол, наличие хронических заболеваний, а также образ жизни, такой как диета и физическая активность. Кроме того, стресс и инфекционные заболевания также могут привести к изменению этого показателя. Поэтому для точной интерпретации PDW важно учитывать все аспекты здоровья пациента.
Советы
СОВЕТ №1
Обратите внимание на значение PDW в контексте других показателей анализа крови. PDW (ширина распределения тромбоцитов) может указывать на различные состояния организма, поэтому важно рассматривать его вместе с другими параметрами, такими как количество тромбоцитов и уровень гемоглобина.
СОВЕТ №2
Если ваш PDW выше нормы, это может свидетельствовать о наличии воспалительных процессов или других заболеваний. Важно не игнорировать это значение и обсудить его с врачом, который может назначить дополнительные исследования для выяснения причин.
СОВЕТ №3
Для коррекции PDW рекомендуется следить за своим питанием. Увеличьте потребление продуктов, богатых витаминами и минералами, такими как фрукты, овощи, орехи и рыба. Это поможет поддерживать здоровье кровеносной системы и нормализовать показатели анализа.
СОВЕТ №4
Регулярные физические нагрузки также могут положительно сказаться на показателях крови, включая PDW. Умеренные аэробные упражнения, такие как ходьба или плавание, способствуют улучшению циркуляции крови и общему состоянию здоровья.